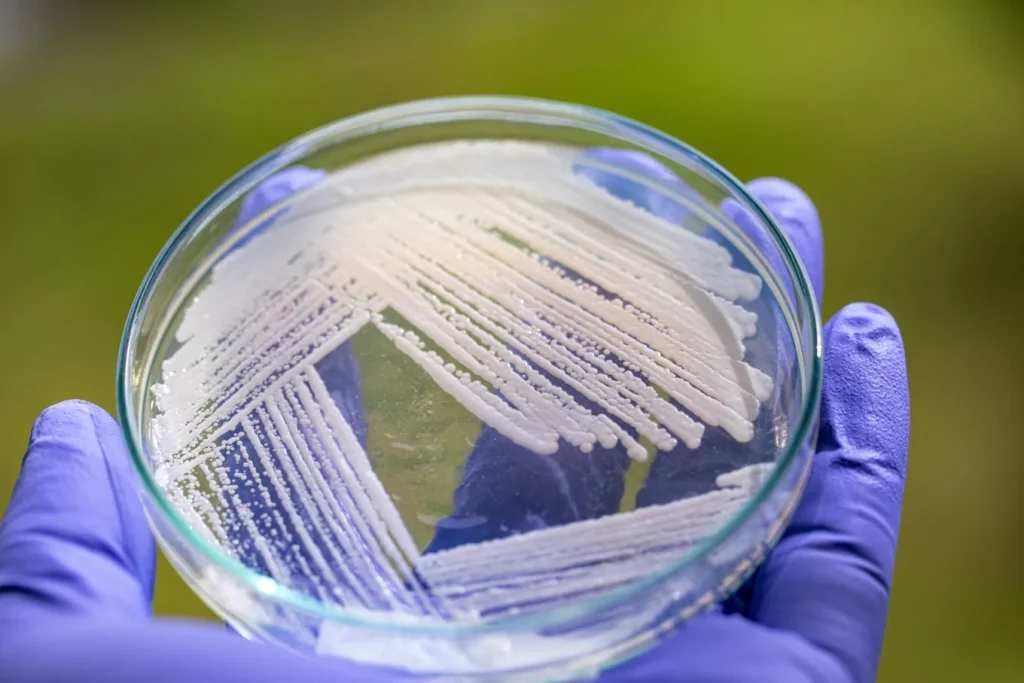
Gist in een petri-schaaltje

Een team internationale wetenschappers, onder leiding van Wageningen University & Research (WUR), is een onderzoek gestart naar hoe en waarom gistcellen doodgaan, en vooral: hoe je dat kunt uitstellen. Die kennis kan een sleutelrol spelen in duurzamere en efficiëntere productie van voedingseiwitten, medicijnen en biobrandstof.
Gisten zijn al eeuwenlang trouwe werkpaarden in de biotechnologie. Niet alleen rijst dit micro-organisme ons brood en fermenteert hij bier en wijn, maar na kleine aanpassingen in het DNA produceert hij ook nuttige stofjes zoals insuline, antilichamen en voedingseiwitten. Helaas gaan gistcellen, onder andere door stress, tijdens het productieproces ook regelmatig dood. Onhandig, want daarbij barsten die cellen open en komt de inhoud vrij. Stofjes uit de cel kunnen het product beschadigen en verontreinigen. “Wij willen eigenlijk zo lang mogelijk met elke gistcel doen”, zegt Mark Bisschops, universitair docent Bioprocess Engineering en coördinator van het project. “Daarvoor moeten we de gist zo gek krijgen dat hij langer leeft én blijft produceren.”
Om dat voor elkaar te krijgen, moeten wetenschappers begrijpen hoe en wanneer gistcellen het loodje leggen. Het project begint daarom bij de basis: begrijpen welke moleculaire routes (en genen) daarbij betrokken zijn. “Zodra we dat weten, kunnen we die routes naar celdood blokkeren, zodat de cel blijft leven,” legt Bisschops uit. Dat kan bijvoorbeeld door genen gericht aan of uit te schakelen die betrokken zijn bij het activeren of tegenhouden van celdood. Toch is het allemaal niet zo eenvoudig. Net als menselijke cellen kennen gisten meerdere vormen van gereguleerde celdood, die steeds via een unieke moleculaire route verlopen. Daarvan weten we nog maar weinig.
Lees het hele bericht op de site van de Wageningen Universiteit.